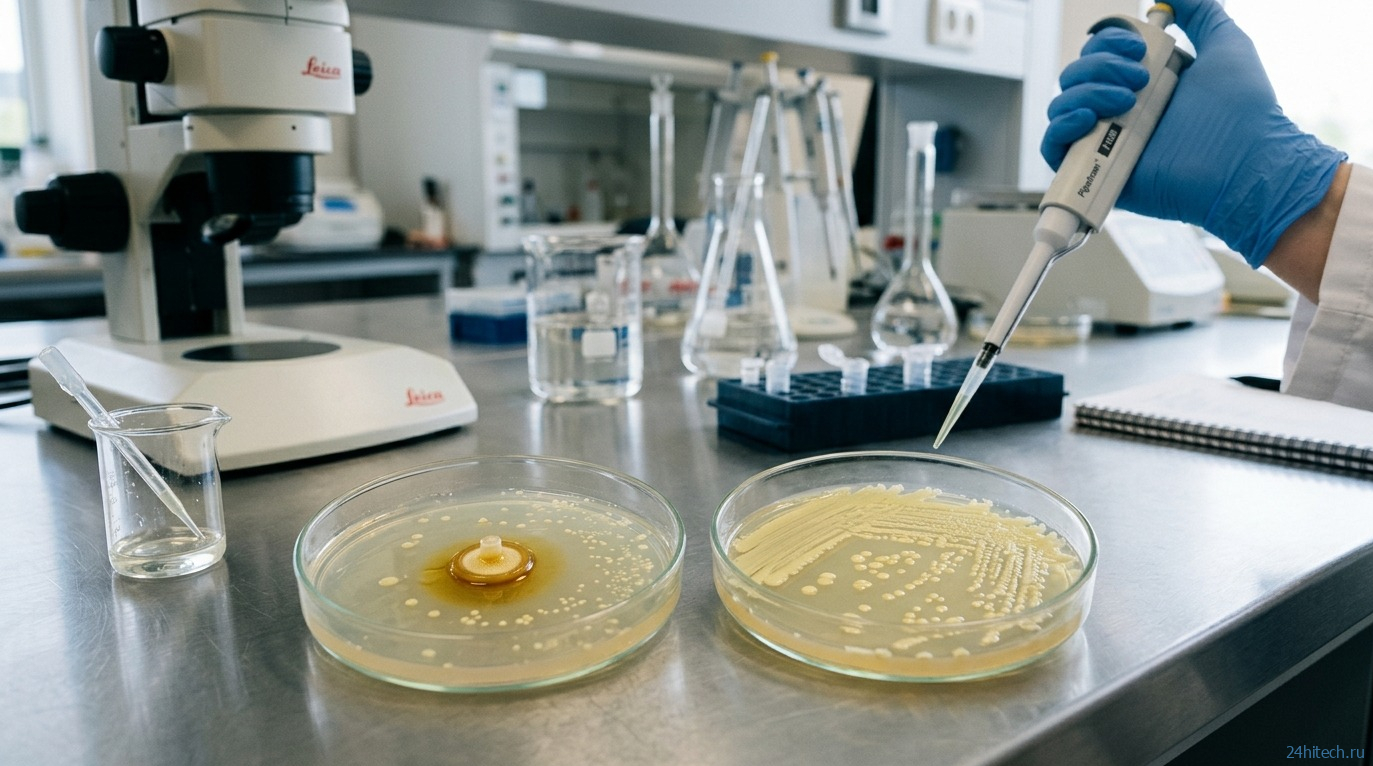

Маленький желтый полевой цветок, который веками использовали в народной медицине Ирландии и Европы, оказался способен бороться с бактериями, устойчивыми к современным антибиотикам. Группа ученых опубликовала исследование, в котором показала, что экстракт корня лапчатки прямостоячей не просто убивает микробы, а усиливает действие антибиотиков и лишает бактерий способности строить защитные укрытия. Это очень важное открытие, особенно учитывая, что устойчивые к антибиотикам бактерии могут мигрировать по организму.
Этот маленький цветок может спасти человечество, и это не преувеличение
Почему антибиотики перестают работать
Чтобы понять, почему скромный цветок из болота вдруг стал интересен ученым, нужно разобраться с масштабом проблемы. Устойчивость к антибиотикам — это способность бактерий выживать несмотря на лекарства, которые раньше их уничтожали. И масштаб этой проблемы пугает.
По данным Science Alert, в 2023 году каждый шестой лабораторно подтвержденный случай бактериальной инфекции в мире характеризовался устойчивостью к антибиотикам. За период с 2018 по 2023 год устойчивость бактерий выросла к 40% антибиотиков, за которыми ведется наблюдение. А масштабное исследование GRAM прогнозирует, что без принятия эффективных мер в период с 2025 по 2050 год общее число смертей, связанных с антибиотикорезистентностью, в мире достигнет 39 миллионов.
Проще говоря, мы рискуем вернуться во времена, когда обычная инфекция после операции или пневмония снова станут смертельно опасными. Именно поэтому ученые ищут новые способы борьбы с бактериями, и один из них нашелся в неожиданном месте.
Что такое лапчатка прямостоячая
Лапчатка прямостоячая (Potentilla erecta) — это невзрачный желтый цветок, который растет на болотах и лугах Ирландии, Великобритании и континентальной Европы. Корень этого растения веками использовали в ирландской и европейской народной медицине: им лечили раны, боль в горле, диарею и заболевания дёсен.
Такая история применения подсказывала: возможно, в этом растении есть что-то, способное убивать микробы. И группа ученых под руководством профессора Ронана Маккарти из Университета Саутгемптона решила это проверить систематически.
В рамках недавнего исследования, опубликованного в журнале Microbiology, команда собрала более 70 видов растений с ирландских болот, приготовила из них экстракты и протестировала их в лаборатории против клинически значимых бактерий — в том числе тех, что вызывают тяжелую пневмонию и инфекции мочевыводящих путей. Из всех кандидатов именно экстракт лапчатки показал наиболее заметный антимикробный эффект.
Лапчатка прямостоячая на ирландском болоте — невзрачный цветок с неожиданным потенциалом
Как экстракт лапчатки убивает бактерии
Результаты тестирования оказались многообещающими. Экстракт продемонстрировал два важных свойства: он подавлял рост бактерий и ограничивал формирование биопленок.
Биопленки — это, пожалуй, одна из самых неприятных уловок бактерий. Представьте бактериальное сообщество, которое окружает себя слизистой броней из полисахаридов. Бактерии внутри биопленок способны выдерживать концентрации антибиотиков в 100 и даже в 1000 раз больше обычных терапевтических доз. Антибиотик просто не может пробиться сквозь эту защиту. Именно поэтому биопленки виновны в большинстве хронических инфекций, которые не поддаются обычному лечению.
То, что экстракт скромного болотного цветка способен ограничивать образование таких защитных структур, действительно важный результат. Но ученые на этом не остановились.
Чем экстракт лапчатки помогает антибиотикам
Отдельная и, пожалуй, самая интригующая часть исследования — попытка совместить растительный экстракт с уже существующими антибиотиками. Дело в том, что некоторые растительные соединения не убивают бактерии напрямую, но делают антибиотики эффективнее, словно открывают дверь, в которую затем заходит лекарство.
Ученые взяли антибиотик колистин — препарат последнего резерва для лечения инфекций, вызванных бактериями с множественной лекарственной устойчивостью. Колистин применяют только в крайних случаях, потому что он токсичен для почек. В низкой дозировке он не справлялся с бактериями сам по себе. Но когда к нему добавили экстракт лапчатки, растительные соединения значительно усилили эффективность антибиотика.
Это принципиально важно. Если растительный экстракт позволяет использовать меньшие дозы токсичного антибиотика и при этом получать лучший результат, это может снизить побочные эффекты для пациентов. Такой подход особенно актуален при тяжелых инфекциях, от бактериальной пневмонии до инфекций мочевыводящих путей, где супербактерии оставляют врачам все меньше вариантов.
Лабораторные чашки Петри с бактериальными культурами: сравнение образцов с экстрактом и без него
Как лапчатка лишает бактерии питания
Исследователи не просто зафиксировали эффект — они разобрались в механизме. Анализ состава экстракта показал, что ключевую роль играют два вещества: эллаговая кислота и агримониин — природные соединения из группы полифенолов, известные своими антиоксидантными и противовоспалительными свойствами.
Корень лапчатки исключительно богат полифенолами — танины составляют до 20–25% сухой массы. Именно эти вещества оказались антимикробно активными.
Ученые выяснили, что эти соединения работают, «вычищая» железо из окружающей среды бактерий. Железо — критически важный для бактерий ресурс, без которого они не могут размножаться. По сути, растительные молекулы лишали бактериальные клетки необходимого питания, не давая им расти.
Это элегантный и при этом совершенно иной механизм по сравнению с большинством антибиотиков. Обычные антибиотики разрушают стенку бактериальной клетки, мешают синтезу белков или ДНК. А здесь — осада: бактерию не убивают в лоб, а перекрывают ей снабжение. Бактериям сложнее выработать устойчивость к такому подходу, потому что потребность в железе — их базовое ограничение.
Схематическое изображение механизма: растительные молекулы перехватывают железо, лишая бактерии ресурса для роста
Когда ожидать лекарства на основе лапчатки
Важно понимать: это исследование проведено в лаборатории, а не на людях. Сейчас ученые сосредоточены на оптимизации антимикробной активности и разработке составов для тестирования на экспериментальных моделях. До клинических испытаний на пациентах еще долгий путь.
Исследование лапчатки прямостоячей — это не готовое лекарство, а обоснованная отправная точка. Оно показывает конкретный механизм действия, конкретные молекулы и конкретный синергетический эффект с уже существующим антибиотиком. Это гораздо больше, чем расплывчатое «народная медицина работает». И оно напоминает, что ответ на одну из главных угроз современной медицины, возможно, растет у нас буквально под ногами.

Нет комментарий